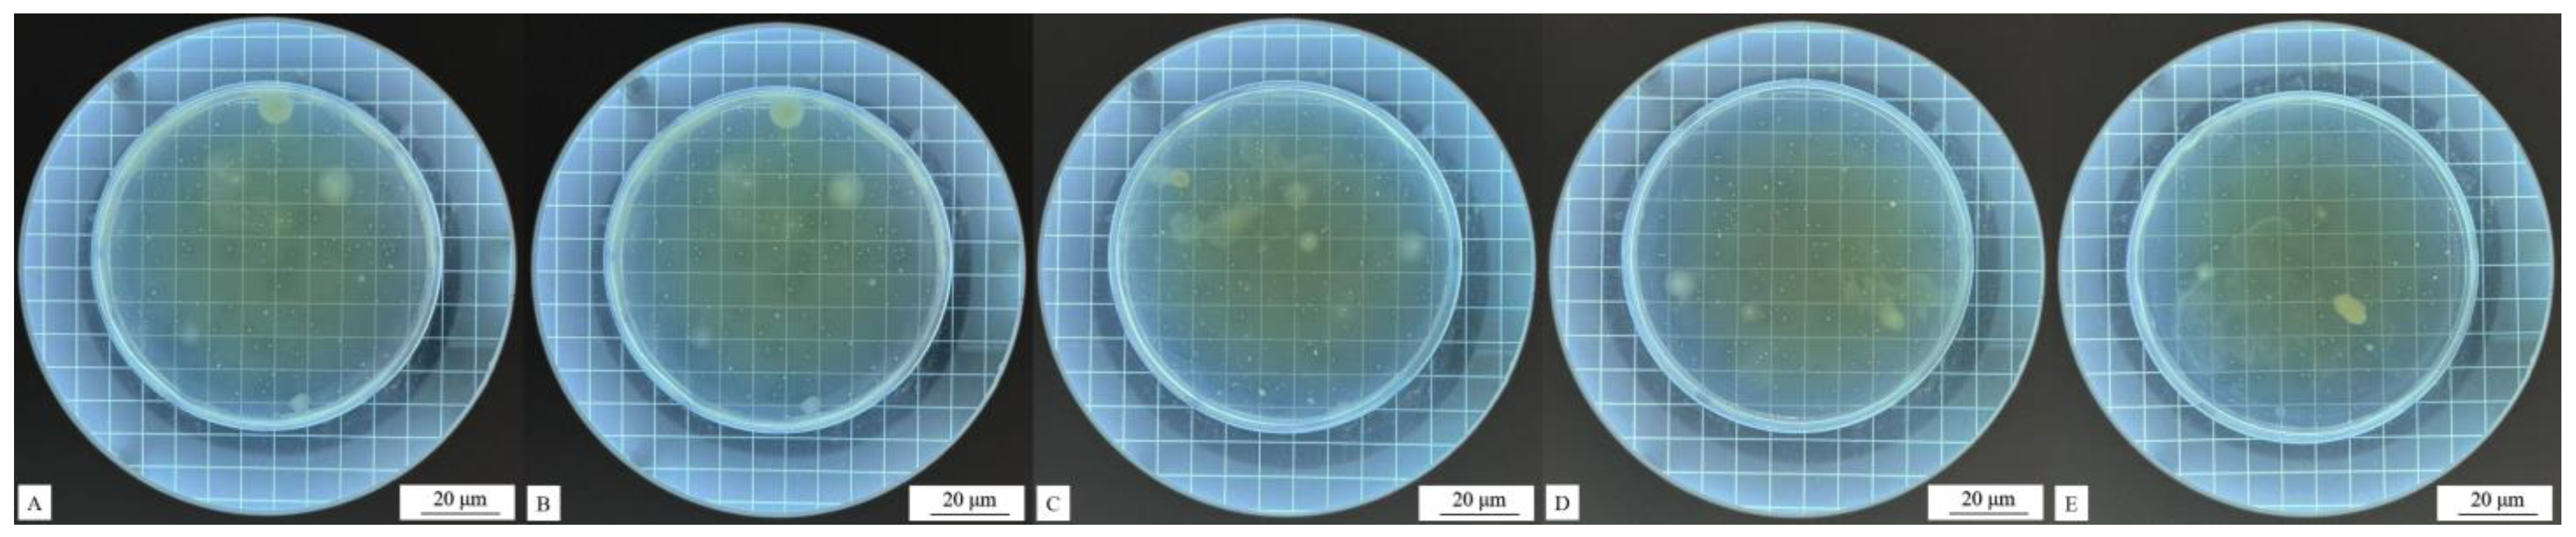
Coatings 14 01011 g010
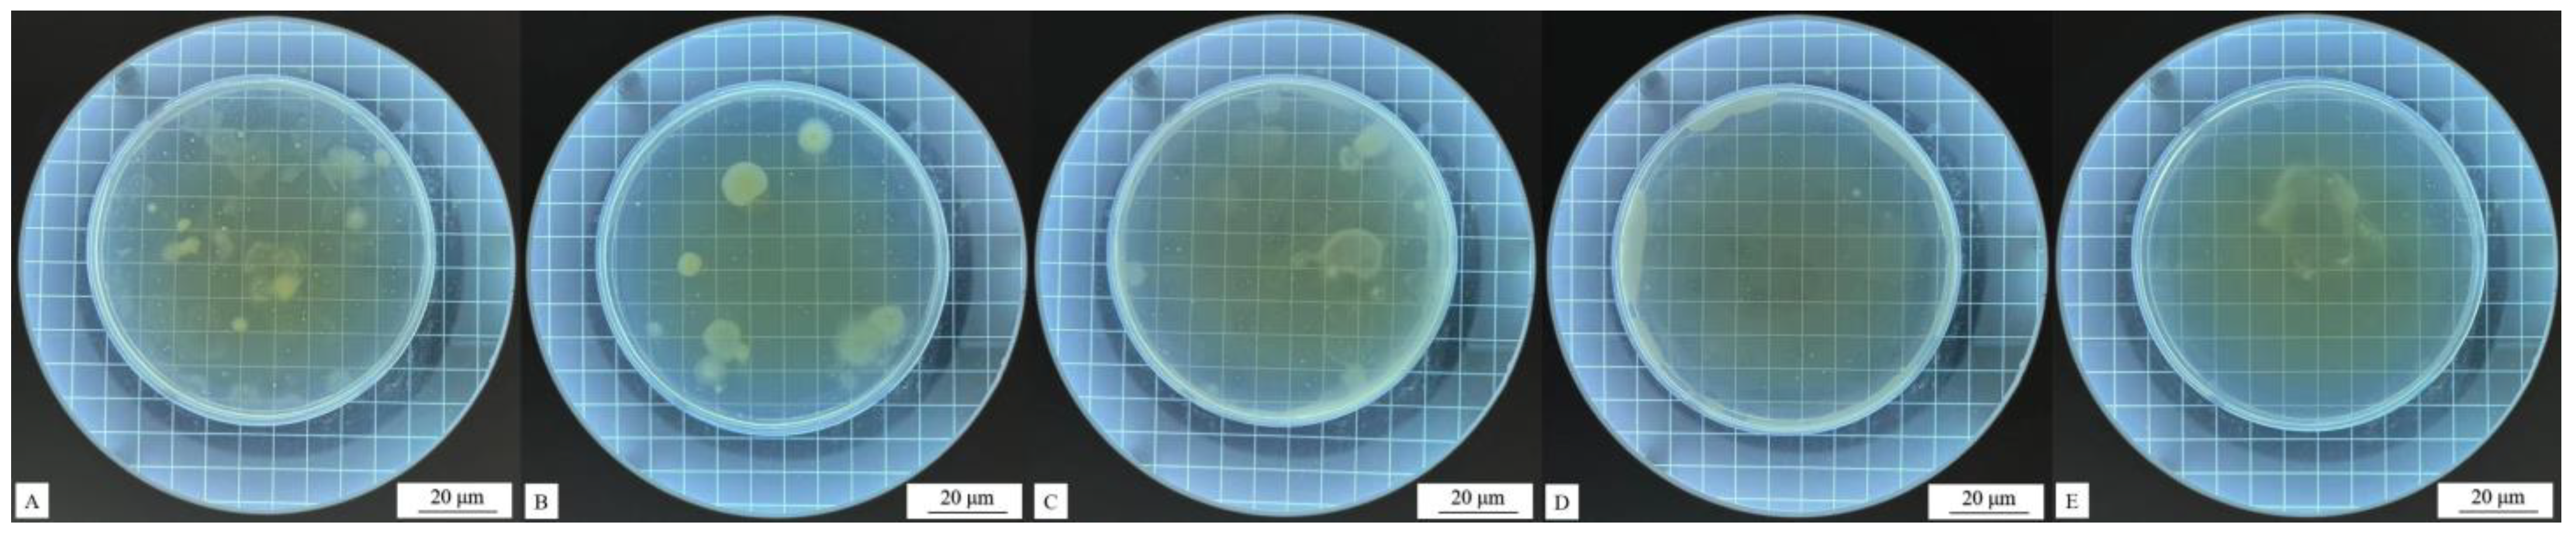
Coatings 14 01011 g011

The Effects of Urea–Formaldehyde Resin-Coated Toddalia asiatica (L.) Lam Extract Microcapsules on the Properties of Surface Coatings for Poplar Wood
Abstract
1. Introduction
2. Materials and Methods
2.1. Materials and Instruments
2.2. Preparation Method of Microcapsules
2.2.1. Preparation Method of Toddalia asiatica (L.) Lam Extract
2.2.2. Preparation Method of Microcapsules
2.3. Painting Method for Poplar Board
2.4. Testing and Characterization
2.4.1. Performance Characterization of Microcapsules
- (1)
- Coverage rate (C): UFRCTEMs with a mass of M1 were weighed. M2 was the weight of the weighing filter paper. The UFRCTEMs were soaked in ethanol, filtered, and dried after 24 h. The total mass of the dried filter paper and wall material was M3. The calculation of the coverage rate is shown in Formula (1).
- (2)
- Yield rate (Y): The total mass of materials used for preparing the UFRCTEM samples was denoted as M1. The mass of the UFRCTEMs after drying was recorded as M2. The calculation of the yield rate is shown in Formula (2).
- (3)
- Analysis of microstructure and chemical composition: a Zeiss optical microscope (OM, Carl Zeiss AG, Oberkochen, Germany) was used to observe the morphology of the UFRCTEMs. Scanning electron microscopy (SEM, Tescan, Brno, the Czech Republic) was used to analyze the microstructure of the UFRCTEMs and coatings. Fourier-transform infrared spectroscopy (FTIR, Brucker AG, Karlsruhe, Germany) was used to analyze the chemical composition of the UFRCTEMs and coatings.
2.4.2. Color Difference Testing of Coatings
2.4.3. Test for Glossiness and Reflectivity of Coatings
2.4.4. Roughness Testing of Coatings
2.4.5. Cold Liquid Resistance Test of Coatings
2.4.6. Antibacterial Performance Testing of Coatings
2.4.7. Hardness, Impact Resistance, and Adhesion Testing of Coatings
3. Results and Discussion
3.1. Morphology and Chemical Composition Analysis of Microcapsules
3.1.1. Microscopic Morphology Analysis of Microcapsules
3.1.2. Chemical Composition Analysis of Microcapsules
3.2. Optical Performance Analysis of Coatings
3.3. Cold Liquid Resistance of Coatings
3.4. Mechanical Properties of Surface Coatings
3.4.1. Hardness of Surface Coating on Poplar Wood
3.4.2. Impact Resistance of Surface Coating on Poplar Wood
3.4.3. Adhesion of Surface Coating on Poplar Wood
3.4.4. Roughness of Surface Coating on Poplar Wood
3.5. Antibacterial Properties of Surface Coatings on Poplar Wood
3.6. Microscopic Morphology and Chemical Composition of Surface Coating on Poplar Wood
3.7. Sectional Views Coatings with Different Mcore:Mwall on Wood Surface
4. Conclusions
Author Contributions
Funding
Institutional Review Board Statement
Informed Consent Statement
Data Availability Statement
Conflicts of Interest
References
- Brezina, D.; Michal, J.; Hlavácková, P. The Impact of Natural Disturbances on the Central European Timber Market—An Analytical Study. Forests 2024, 15, 592. [Google Scholar] [CrossRef]
- Wang, C.; Yu, J.H.; Jiang, M.H.; Li, J.Y. Effect of selective enhancement on the bending performance of fused deposition methods 3D-printed PLA models. BioResources 2024, 19, 2660–2669. [Google Scholar] [CrossRef]
- Wu, W.; Xu, W.; Wu, S. Mechanical performance analysis of double-dovetail joint applied to furniture T-shaped components. BioResources 2024, 19, 5862–5879. [Google Scholar] [CrossRef]
- Zhang, N.; Xu, W.; Tan, Y. Multi-attribute hierarchical clustering for product family division of customized wooden doors. Bioresources 2023, 18, 7889–7904. [Google Scholar] [CrossRef]
- Singh, A.P.; Kim, Y.S.; Chavan, R.R. Relationship of wood cell wall ultrastructure to bacterial degradation of wood. IAWA J. 2019, 40, 845–870. [Google Scholar] [CrossRef]
- Hu, J.; Liu, Y.; Wang, J.X.; Xu, W. Study of selective modification effect of constructed structural color layers on European beech wood surfaces. Forests 2024, 15, 261. [Google Scholar] [CrossRef]
- Hu, W.; Yu, R. Study on the strength mechanism of the wooden round-end mortise-and-tenon joint using the digital image correlation method. Holzforschung 2024. [Google Scholar] [CrossRef]
- Hu, W.G.; Li, S.; Liu, Y. Vibrational characteristics of four wood species commonly used in wood products. BioResources 2021, 16, 7100–7110. [Google Scholar] [CrossRef]
- Wu, S.S.; Tao, X.; Xu, W. Thermal conductivity of poplar wood veneer impregnated with graphene/polyvinyl alcohol. Forests 2021, 12, 777. [Google Scholar] [CrossRef]
- Wu, S.S.; Zhou, J.C.; Xu, W. A convenient approach to manufacturing lightweight and high-sound-insulation plywood using furfuryl alcohol/multilayer graphene oxide as a shielding layer. Wood Mater. Sci. Eng. 2024, 1–8. [Google Scholar] [CrossRef]
- Hu, W.G.; Liu, N.; Guan, H.Y. Experimental and numerical study on methods of testing withdrawal resistance of mortise-and-tenon joint for Wood products. Forests 2020, 11, 280. [Google Scholar] [CrossRef]
- Qi, Y.Q.; Zhang, Z.Q.; Sun, Y.; Shen, L.M.; Han, J.L. Study on the process optimization of peanut coat pigment staining of poplar wood. Forests 2024, 15, 504. [Google Scholar] [CrossRef]
- Qi, Y.Q.; Sun, Y.; Zhou, Z.W.; Huang, Y.; Li, J.X.; Liu, G.Y. Response surface optimization based on freeze-thaw cycle pretreatment of poplar wood dyeing effect. Wood Res. 2023, 68, 293–305. [Google Scholar] [CrossRef]
- Wu, X.Y.; Yang, F.; Gan, J.; Kong, Z.Q.; Wu, Y. A Superhydrophobic, Antibacterial, and Durable Surface of Poplar Wood. Nanomaterials 2021, 11, 1885. [Google Scholar] [CrossRef]
- Wan, B.Y.; Tian, L.X.; Fu, M.; Zhang, G.Y. Green development growth momentum under carbon neutrality scenario. J. Clean. 2021, 316, 128327. [Google Scholar] [CrossRef]
- Wang, C.; Zhang, C.Y.; Zhu, Y. Reverse design and additive manufacturing of furniture protective foot covers. BioResources 2024, 19, 4670–4678. [Google Scholar] [CrossRef]
- Zhao, Z.N.; Niu, Y.T.; Chen, F.Y. Development and Finishing Technology of Waterborne UV Lacquer-Coated Wooden Flooring. BioResources 2021, 16, 1101–1114. [Google Scholar] [CrossRef]
- Tompros, A.; Wilber, M.Q.; Fenton, A.; Carter, E.D.; Gray, M.J. Efficacy of Plant-Derived Fungicides at Inhibiting Batrachochytrium salamandrivorans Growth. J. Fungi 2022, 8, 1025. [Google Scholar] [CrossRef]
- Sang, R.J.; Yang, F. Effect of TiO2@CaCO3 waterborne primer on the coloring performance of inkjet-printed wood product coatings. Coatings 2023, 13, 2071. [Google Scholar] [CrossRef]
- Sang, R.J.; Yang, F.; Fan, Z.X. The effect of water-based primer pretreatment on the performance of water-based inkjet coatings on wood surfaces. Coatings 2023, 13, 1649. [Google Scholar] [CrossRef]
- Martins, C.H.G. Antibacterial Agents from Natural Sources. Molecules 2024, 29, 644. [Google Scholar] [CrossRef]
- Qi, Y.Q.; Zhou, Z.W.; Xu, R.; Dong, Y.T.; Liu, M.J.; Shen, L.M.; Han, J.L. Research on the dyeing properties of Chinese fir using ultrasonic-assisted mulberry pigment dyeing. Forests 2023, 14, 1832. [Google Scholar] [CrossRef]
- Qi, Y.Q.; Liu, G.Y.; Zhang, Z.; Zhou, Z.W. Optimization of green extraction process of Cinnamomum camphora fruit dye and its performance by response surface methodology. BioResources 2023, 18, 4916–4934. [Google Scholar] [CrossRef]
- Faccio, G. Plant Complexity and Cosmetic Innovation. iScience 2020, 23, 101358. [Google Scholar] [CrossRef]
- Aziz, I.M.; Alshalan, R.M.; Rizwana, H.; Alkhelaiwi, F.; Almuqrin, A.M.; Aljowaie, R.M.; Alkubaisi, N.A. Chemical Composition, Antioxidant, Anticancer, and Antibacterial Activities of Roots and Seeds of Ammi visnaga L. Methanol Extract. Pharmaceuticals 2024, 17, 121. [Google Scholar] [CrossRef] [PubMed]
- Li, P.; Lei, K.; Ji, L.S. Characterization of the complete chloroplast genome of Toddalia asiatica (L.) Lam. Mitochondrial DNA B 2021, 16, 1650–1651. [Google Scholar] [CrossRef] [PubMed]
- Zeng, Z.; Tian, R.; Feng, J.; Yang, N.A.; Yuan, L. A systematic review on traditional medicine Toddalia asiatica (L.) Lam.: Chemistry and medicinal potential. Saudi Pharm. J. 2021, 29, 781–798. [Google Scholar] [CrossRef]
- Kowalczyk, P.; Koszelewski, D.; Brodzka, A.; Kramkowski, K.; Ostaszewski, R. Evaluation of Antibacterial Activity against Nosocomial Pathogens of an Enzymatically Derived α-Aminophosphonates Possessing Coumarin Scaffold. Int. J. Mol. Sci. 2023, 24, 14886. [Google Scholar] [CrossRef]
- Li, Y.D.; Guan, J.P.; Tang, R.C.; Qiao, Y.F. Application of Natural Flavonoids to Impart Antioxidant and Antibacterial Activities to Polyamide Fiber for Health Care Applications. Antioxidants 2019, 8, 301. [Google Scholar] [CrossRef]
- Yan, Y.M.; Li, X.; Zhang, C.H.; Lv, L.J.; Gao, B.; Li, M.H. Research Progress on Antibacterial Activities and Mechanisms of Natural Alkaloids: A Review. Antibiotics 2021, 10, 318. [Google Scholar] [CrossRef]
- Masyita, A.; Sari, R.M.; Astuti, A.D.; Yasir, B.; Rumata, N.R.; Bin Emran, T.; Nainu, F.; Simal-Gandara, J. Terpenes and terpenoids as main bioactive compounds of essential oils, their roles in human health and potential application as natural food preservatives. Food Chem. X 2022, 13, 100217. [Google Scholar] [CrossRef] [PubMed]
- Raj, M.K.; Balachandran, C.; Duraipandiyan, V.; Agastian, P.; Ignacimuthu, S. Antimicrobial activity of Ulopterol isolated from Toddalia asiatica (L.) Lam.: A traditional medicinal plant. J. Ethnopharmacol. 2012, 140, 161–165. [Google Scholar]
- Roshan, A.B.; Venkatesh, H.N.; Dubery, N.K.; Mohana, D.C. Chitosan-based nanoencapsulation of Toddalia asiatica (L.) Lam. essential oil to enhance antifungal and aflatoxin B1 inhibitory activities for safe storage of maize. Int. J. Biol. Macromol. 2022, 204, 476–484. [Google Scholar] [CrossRef] [PubMed]
- Zhu, Y.; Wang, Y.; Yan, X.X. Preparation of chitosan-coated Toddalia asiatica (L.) Lam extract microcapsules and its effect on coating antibacterial properties. Coatings 2024, 14, 942. [Google Scholar] [CrossRef]
- Wang, Y.; Yan, X.X. Preparation of Toddalia asiatica (L.) Lam. Extract Microcapsules and Their Effect on Optical, Mechanical and Antibacterial Performance of Waterborne Topcoat Paint Films. Coatings 2024, 14, 655. [Google Scholar] [CrossRef]
- GB/T 11186.3-1989; Methods for Measuring the Color of Coatings—Part 3: Calculation of Color Difference. Standardization Administration of the People’s Republic of China: Beijing, China, 1989.
- GB/T 4893.6-2013; Testing of Physical and Chemical Properties of Furniture Surface Paint Films—Part 6: Gloss Determination Method. Standardization Administration of the People’s Republic of China: Beijing, China, 2013.
- GB/T 4893.1-2021; Test of Surface Coatings of Furniture—Part 1: Determination of Surface Resistance to Cold Liquids. Stanardization Administration of the People’s Republic of China: Beijing, China, 2021.
- GB/T 21866-2008; Test Method and Effect for Antibacterial Capability of Paints Film. Standardization Administration of the People’s Republic of China: Beijing, China, 2008.
- GB/T 4789.2-2022; Microbiological Examination of Food Hygiene—Aerobic Plate Count. Standardization Administration of the People’s Republic of China: Beijing, China, 2022.
- GB/T 6739-2022; Paints and Varnishes—Determination of Film Hardness by Pencil Test. Standardization Administration of the People’s Republic of China: Beijing, China, 2022.
- GB/T 4893.9-2013; Test of Surface Coatings of Furniture—Part 9: Determination of Resistance to Impact. Standardization Administration of the People’s Republic of China: Beijing, China, 2013.
- GB/T 4893.4-2013; Test of Surface Coating of Furniture—Part 4: Determination of Adhesion by Cross-Cut. Standardization Administration of the People’s Republic of China: Beijing, China, 2013.
- Ma, W.Y.; Ali, I.; Li, Y.L.; Hussain, H.; Zhao, H.Z.; Sun, X.; Xie, L.; Cui, L.; Wang, D.J. A Simple and Efficient Two-Dimensional High-Speed Counter-Current Chromatography Linear Gradient and Isocratic Elution Modes for the Preparative Separation of Coumarins from Roots of Toddalia asiatica (Linn.) Lam. Molecules 2021, 26, 5986. [Google Scholar] [CrossRef] [PubMed]
- Yan, X.X.; Tao, Y.; Qian, X.Y. Preparation and Optimization of Waterborne Acrylic Core Microcapsules for Waterborne Wood Coatings and Comparison with Epoxy Resin Core. Polymers 2020, 12, 2366. [Google Scholar] [CrossRef] [PubMed]
- Gangopadhyay, A. Plant-derived natural coumarins with anticancer potentials: Future and challenges. J. Herb. Med. 2023, 42, 100797. [Google Scholar] [CrossRef]
- Zhou, J.C.; Xu, W. A fast method to prepare highly isotropic and optically adjustable transparent wood-based composites based on interface optimization. Ind. Crops Prod. 2024, 218, 118898. [Google Scholar] [CrossRef]
- Hu, J.; Liu, Y.; Xu, W. Impact of cellular structure on the thickness and light reflection properties of structural color layers on diverse wood surfaces. Wood Mater. Sci. Eng. 2024, 1–11. [Google Scholar] [CrossRef]
- Lim, T.; Bae, S.H.; Yu, S.H.; Baek, K.Y.; Cho, S. Near-Infrared Reflective Dark-Tone Bilayer System for LiDAR-Based Autonomous Vehicles. Macromol. Res. 2022, 30, 342–347. [Google Scholar] [CrossRef]
- Hu, W.G.; Wan, H. Comparative study on weathering durability properties of phenol formaldehyde resin modified sweetgum and southern pine specimens. Maderas Cienc. Tecnol. 2022, 24, 100417. [Google Scholar] [CrossRef]
- Hazir, E.; Koc, K.H. Evaluation of wood surface coating performance using water based, solvent based and powder coating. Maderas Cienc. Tecnol. 2019, 21, 467–480. [Google Scholar] [CrossRef]
- GB/T 3324-2017; General Technical Requirements for Wooden Furniture. Standardization Administration of the People’s Republic of China: Beijing, China, 2017.
- Jia, X.; Zeng, H.H.; Gao, Q.; Huang, Z.X.; Bai, X.J.; Zhao, Y.; Zhao, H.F. Impact Resistance and Structural Optimization of POZD Coated Composite Plates. Int. J. Crashworthiness 2023, 28, 601–615. [Google Scholar] [CrossRef]
- Tao, X.; Tian, D.X.; Liang, S.Q.; Li, S.M.; Peng, L.M.; Fu, F. Enhanced Paint Adhesion of Puffed Wood-Based Metal Composites via Surface Treatment with Silane Coupling Agent. Wood Mater. Sci. Eng. 2023, 19, 573–579. [Google Scholar] [CrossRef]
- Yan, X.X.; Zhao, W.T.; Wang, L.; Qian, X.Y. Effect of Microcapsule Concentration with Different Core-Shell Ratios on Waterborne Topcoat Film Properties for Tilia europaea. Coatings 2021, 11, 1013. [Google Scholar] [CrossRef]

| Sample (#) | Mcore:Mwall | Urea (g) | 37% Formaldehyde (g) | Wall Material (g) | Toddalia asiatica (L.) Lam Extract (g) | Ethanol (g) | Core Material (g) | Emulsifier (g) | Deionized Water (g) |
|---|---|---|---|---|---|---|---|---|---|
| 1 | 0.6:1 | 10.00 | 16.22 | 16.00 | 0.19 | 9.41 | 9.60 | 1.04 | 50.96 |
| 2 | 0.8:1 | 10.00 | 16.22 | 16.00 | 0.26 | 12.54 | 12.80 | 1.43 | 70.07 |
| 3 | 1.2:1 | 10.00 | 16.22 | 16.00 | 0.38 | 18.82 | 19.20 | 2.09 | 102.41 |
| Microcapsule Content (%) | Waterborne Primer (g) | Microcapsules (g) | Waterborne Topcoat (g) |
|---|---|---|---|
| 0 | 0.720 | 0 | 0.720 |
| 1.0 | 0.720 | 0.007 | 0.713 |
| 3.0 | 0.720 | 0.022 | 0.698 |
| 5.0 | 0.720 | 0.036 | 0.684 |
| 7.0 | 0.720 | 0.051 | 0.669 |
| 9.0 | 0.720 | 0.065 | 0.655 |
| Level | Changes in Coating on Wood Surface |
|---|---|
| 1 | No visible changes (no damage). |
| 2 | No cracks on the surface of the coating, but visible impact marks. |
| 3 | There are mild cracks on the surface of the coating, usually 1–2 circular or arc cracks. |
| 4 | There are moderate to severe cracks on the surface of the coating, usually 3–4 circular or arc cracks. |
| 5 | The surface of the coating is severely damaged, with usually more than 5 cycles of ring cracks, arc cracks, or coating detachment. |
| Sample (#) | Mcore:Mwall | Microcapsule Content (%) | Glossiness (GU) | Light Loss Rate (%) | ||
|---|---|---|---|---|---|---|
| 20° | 60° | 85° | ||||
| - | - | 0 | 2.20 | 14.03 | 33.23 | - |
| Surface coating on poplar wood with #1 microcapsules added | 0.6:1 | 1.0 | 1.87 | 7.17 | 10.57 | 48.90 |
| 3.0 | 1.33 | 5.20 | 2.33 | 62.94 | ||
| 5.0 | 1.10 | 4.40 | 1.53 | 68.64 | ||
| 7.0 | 1.17 | 4.30 | 1.10 | 69.35 | ||
| 9.0 | 0.90 | 2.53 | 0.87 | 81.97 | ||
| Surface coating on poplar wood with #2 microcapsules added | 0.8:1 | 1.0 | 1.60 | 7.00 | 9.93 | 50.11 |
| 3.0 | 1.40 | 6.23 | 2.77 | 55.60 | ||
| 5.0 | 1.23 | 4.60 | 1.13 | 67.21 | ||
| 7.0 | 1.13 | 3.43 | 0.93 | 75.55 | ||
| 9.0 | 0.97 | 2.83 | 0.77 | 79.83 | ||
| Surface coating on poplar wood with #3 microcapsules added | 1.2:1 | 1.0 | 1.63 | 8.50 | 14.30 | 39.42 |
| 3.0 | 1.40 | 6.17 | 3.43 | 56.02 | ||
| 5.0 | 1.27 | 4.30 | 1.57 | 69.35 | ||
| 7.0 | 1.13 | 3.80 | 1.00 | 72.92 | ||
| 9.0 | 0.87 | 2.80 | 0.93 | 80.04 | ||
| Sample (#) | Mcore:Mwall | Microcapsule Content (%) | Chromaticity Parameter | ΔE | |||||
|---|---|---|---|---|---|---|---|---|---|
| L1 | a1 | b1 | L2 | a2 | b2 | ||||
| - | - | 0 | 82.35 | 5.30 | 29.95 | 82.25 | 5.55 | 29.85 | - |
| Surface coating on poplar wood with #1 UFRCTEM added | 0.6:1 | 1 | 81.90 | 6.25 | 28.85 | 81.50 | 6.10 | 28.70 | 0.98 |
| 3 | 78.35 | 8.75 | 27.00 | 78.20 | 8.20 | 26.60 | 2.41 | ||
| 5 | 76.25 | 10.20 | 27.15 | 76.05 | 9.80 | 27.10 | 3.39 | ||
| 7 | 77.50 | 8.20 | 30.45 | 77.20 | 8.05 | 29.80 | 2.01 | ||
| 9 | 69.25 | 12.35 | 29.50 | 69.00 | 11.95 | 29.45 | 6.53 | ||
| Surface coating on poplar wood with #2 UFRCTEM added | 0.8:1 | 1 | 81.55 | 4.25 | 26.65 | 81.50 | 4.20 | 26.70 | 1.83 |
| 3 | 79.65 | 7.15 | 28.05 | 79.25 | 6.85 | 27.75 | 1.35 | ||
| 5 | 75.95 | 10.40 | 27.35 | 75.65 | 10.15 | 26.80 | 3.60 | ||
| 7 | 76.35 | 8.15 | 25.75 | 76.15 | 7.90 | 25.45 | 3.23 | ||
| 9 | 75.60 | 11.95 | 28.55 | 75.10 | 11.70 | 28.05 | 4.13 | ||
| Surface coating on poplar wood with #3 UFRCTEM added | 1.2:1 | 1 | 78.90 | 6.85 | 27.70 | 78.70 | 6.45 | 27.60 | 1.49 |
| 3 | 78.40 | 6.30 | 31.00 | 78.05 | 6.20 | 30.70 | 1.22 | ||
| 5 | 75.55 | 7.25 | 30.30 | 75.50 | 6.85 | 30.40 | 2.54 | ||
| 7 | 76.10 | 7.65 | 30.00 | 76.05 | 7.35 | 29.60 | 2.36 | ||
| 9 | 76.65 | 9.15 | 27.65 | 76.10 | 8.95 | 27.25 | 2.94 | ||
| Microcapsule Content (%) | Reflectance R Value of Surface Coating on Poplar Wood | ||
|---|---|---|---|
| 0.6:1 | 0.8:1 | 1.2:1 | |
| 0 | 0.6193 | 0.6193 | 0.6193 |
| 1.0 | 0.6472 | 0.5652 | 0.6298 |
| 3.0 | 0.6014 | 0.6399 | 0.6176 |
| 5.0 | 0.5890 | 0.6144 | 0.5715 |
| 7.0 | 0.6250 | 0.6699 | 0.6310 |
| 9.0 | 0.5770 | 0.5899 | 0.5471 |
| Sample (#) | Mcore:Mwall | Microcapsule Content (%) | Cold Liquid Resistance Level of Surface Coating on Poplar Wood (Level) | ||
|---|---|---|---|---|---|
| Citric Acid | Ethanol | Cleaning Agents | |||
| - | - | 0 | 2 | 3 | 3 |
| Surface coating on poplar wood with #1 UFRCTEMs added | 0.6:1 | 1 | 1 | 2 | 3 |
| 3 | 1 | 2 | 2 | ||
| 5 | 1 | 2 | 2 | ||
| 7 | 1 | 1 | 2 | ||
| 9 | 1 | 1 | 1 | ||
| Surface coating on poplar wood with #2 UFRCTEMs added | 0.8:1 | 1 | 1 | 2 | 2 |
| 3 | 1 | 2 | 2 | ||
| 5 | 1 | 2 | 2 | ||
| 7 | 1 | 1 | 1 | ||
| 9 | 1 | 1 | 1 | ||
| Surface coating on poplar wood with #3 UFRCTEMs added | 1.2:1 | 1 | 1 | 2 | 2 |
| 3 | 1 | 2 | 2 | ||
| 5 | 1 | 1 | 1 | ||
| 7 | 1 | 1 | 1 | ||
| 9 | 1 | 1 | 1 | ||
| Microcapsule Content (%) | Hardness | ||
|---|---|---|---|
| 0.6:1 | 0.8:1 | 1.2:1 | |
| 0 | B | B | B |
| 1.0 | B | B | B |
| 3.0 | HB | HB | HB |
| 5.0 | HB | HB | 2H |
| 7.0 | HB | 2H | 2H |
| 9.0 | 2H | 2H | 3H |
| Microcapsule Content (%) | Impact Resistance Level (Level) | ||
|---|---|---|---|
| 0.6:1 | 0.8:1 | 1.2:1 | |
| 0 | 5 | 5 | 5 |
| 1.0 | 4 | 4 | 4 |
| 3.0 | 4 | 4 | 3 |
| 5.0 | 4 | 3 | 3 |
| 7.0 | 3 | 3 | 3 |
| 9.0 | 3 | 3 | 3 |
| Microcapsule Content (%) | Adhesion Level (Level) | ||
|---|---|---|---|
| 0.6:1 | 0.8:1 | 1.2:1 | |
| 0 | 0 | 0 | 0 |
| 1.0 | 1 | 1 | 1 |
| 3.0 | 1 | 1 | 1 |
| 5.0 | 1 | 1 | 1 |
| 7.0 | 1 | 1 | 2 |
| 9.0 | 2 | 2 | 2 |
| Microcapsule Content (%) | Roughness (µm) | ||
|---|---|---|---|
| 0.6:1 | 0.8:1 | 1.2:1 | |
| 0 | 0.260 | 0.260 | 0.260 |
| 1.0 | 1.030 | 0.951 | 1.387 |
| 3.0 | 2.806 | 2.457 | 2.194 |
| 5.0 | 2.161 | 3.407 | 2.508 |
| 7.0 | 3.522 | 3.759 | 3.947 |
| 9.0 | 4.571 | 4.961 | 4.226 |
| Mcore:M wall | Microcapsule Content (%) | Average Number of Recovered Escherichia coli (CFU·Piece−1) | Antibacterial Rate of Escherichia coli (%) | Average Number of Recovered Staphylococcus aureus (CFU·Piece−1) | Antibacterial Rate of Staphylococcus aureus (%) |
|---|---|---|---|---|---|
| - | 0 | 347 | - | 368 | - |
| 0.6:1 | 1 | 190 | 45.25 | 195 | 47.01 |
| 3 | 135 | 61.10 | 143 | 61.14 | |
| 5 | 124 | 64.27 | 104 | 71.74 | |
| 7 | 96 | 72.33 | 98 | 73.37 | |
| 9 | 95 | 72.62 | 77 | 79.08 | |
| 0.8:1 | 1 | 197 | 43.22 | 181 | 50.82 |
| 3 | 153 | 55.91 | 139 | 62.23 | |
| 5 | 125 | 63.98 | 101 | 72.55 | |
| 7 | 109 | 68.59 | 91 | 75.27 | |
| 9 | 98 | 71.76 | 73 | 80.16 | |
| 1.2:1 | 1 | 180 | 48.13 | 147 | 60.05 |
| 3 | 143 | 58.79 | 135 | 63.32 | |
| 5 | 122 | 64.84 | 103 | 72.01 | |
| 7 | 104 | 70.03 | 89 | 75.82 | |
| 9 | 96 | 72.33 | 85 | 76.90 |
Disclaimer/Publisher’s Note: The statements, opinions and data contained in all publications are solely those of the individual author(s) and contributor(s) and not of MDPI and/or the editor(s). MDPI and/or the editor(s) disclaim responsibility for any injury to people or property resulting from any ideas, methods, instructions or products referred to in the content. |
© 2024 by the authors. Licensee MDPI, Basel, Switzerland. This article is an open access article distributed under the terms and conditions of the Creative Commons Attribution (CC BY) license (https://creativecommons.org/licenses/by/4.0/).
Share and Cite
Zhu, Y.; Wang, Y.; Yan, X. The Effects of Urea–Formaldehyde Resin-Coated Toddalia asiatica (L.) Lam Extract Microcapsules on the Properties of Surface Coatings for Poplar Wood. Coatings 2024, 14, 1011. https://doi.org/10.3390/coatings14081011
Zhu Y, Wang Y, Yan X. The Effects of Urea–Formaldehyde Resin-Coated Toddalia asiatica (L.) Lam Extract Microcapsules on the Properties of Surface Coatings for Poplar Wood. Coatings. 2024; 14(8):1011. https://doi.org/10.3390/coatings14081011
Chicago/Turabian StyleZhu, Ye, Ying Wang, and Xiaoxing Yan. 2024. "The Effects of Urea–Formaldehyde Resin-Coated Toddalia asiatica (L.) Lam Extract Microcapsules on the Properties of Surface Coatings for Poplar Wood" Coatings 14, no. 8: 1011. https://doi.org/10.3390/coatings14081011
APA StyleZhu, Y., Wang, Y., & Yan, X. (2024). The Effects of Urea–Formaldehyde Resin-Coated Toddalia asiatica (L.) Lam Extract Microcapsules on the Properties of Surface Coatings for Poplar Wood. Coatings, 14(8), 1011. https://doi.org/10.3390/coatings14081011
